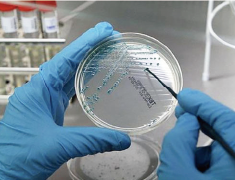
抗菌作用に関する特許

速攻×安全×簡易
避難用具エスケープシリーズで
災害時の緊急避難をより早く、安全に、確実に!
速攻×安全×簡易
避難用具エスケープシリーズで
災害時の緊急避難をより早く、安全に、確実に!
FEATURES
エスケープシリーズの特徴
誰も置き去りにしない。
LEABE NO ONE BEHIND
エスケープシリーズはオランダで開発された
新発想の緊急避難用具です。
病院や高齢者施設、さらに企業、学校、ホテル・マンション、工場、
公共機関等が災害に見舞われた時、
スムーズに動けない方や自力で歩けない方の
移動をより完全、かつスピーディーに行うことを可能にします。
これまで避難搬送具導入には、コスト面の問題や、
避難を担うマンパワーの確保の問題など、
クリアしなければならない様々な課題を抱えていました。


特に地震等の自然災害の多い国や地域の高齢化により
介護や看護を必要とする方が増加する国々、高層ビルの多い
地域などでは深刻な問題となっています。
そのような状況の中で「安全性」はもちろん
「スピード」「使いやすさ」を追求して誕生したのが、
このエスケープシリーズです。
FEATURES
エスケープシリーズの特徴
誰も置き去りにしない。
LEABE NO ONE BEHIND
エスケープシリーズはオランダで開発された新発想の緊急避難用具です。
病院や高齢者施設、さらに企業、学校、ホテル・マンション、工場、公共機関等が災害に見舞われた時、
スムーズに動けない方や自力で歩けない方の移動をより完全、かつスピーディーに行うことを可能にします。
これまで避難搬送具導入には、コスト面の問題や、避難を担うマンパワーの確保の問題など、クリアしなければならない様々な課題を抱えていました。

特に地震等の自然災害の多い国や地域の高齢化により 介護や看護を必要とする方が増加する国々、高層ビルの多い 地域などでは深刻な問題となっています。 そのような状況の中で「安全性」はもちろん 「スピード」「使いやすさ」を追求して誕生したのが、 このエスケープシリーズです。

ABOUT
エスケープシリーズの特徴


速攻
簡易
60秒で移動開始
患者様をシートで包み、マジックテープで接着するだけなので60秒で避難移動を開始できます。

速攻
簡易
誰でもすぐに使える
強力なマジックテープでしっかり固定。誰でも簡単に扱えます。

速攻
安全
1人でも安全に使える
基本的に1人での取り回しができます。引きずって移動するので搬送中の転落事故の心配がありません。

安全
簡易
どんな階段でも使える
らせん階段などでも使用でき、多様な避難経路に対応できます。

簡易
簡単なメンテナンス
洗濯機で洗うことができます。または軽く底面をふくだけで汚れを落とせます。

安全
衝撃を吸収するマット
7.5cmの厚みの特殊マットレスが衝撃を吸収。

簡易
選べる保管方法
キャリーバッグ以外にウォールカバー、フラット保管が選べます。
MATERIAL
高機能な生地を使用

MRSAを含む70種類以上もの幅広い病原菌に効能を発揮。
独ホーヘンシュタイン研究所、ベルギーテキスタイル研究所、仏パスツール研究所による
テスト及び証明を受けています。
| 抗菌性 | 様々な細菌に対する抗菌作用。 細菌・カビ・イースト菌・ブドウ球菌にも効果があります。 |
|---|---|
| 重金属フリー | 銀・ヒ素・ホルムアルデヒドなどは使用しておりません。 |
| 有害物質 分解性フリー |
有害染料、分解性のない原料は使用しておらず、人体にも環境にも害を及ぼしません。 |
| 耐久性 | 工業用洗濯機で75℃で100回洗濯しても、90%以上のバクテリアの減少させることが確認されています。 |
| 難燃性 | 世界標準の防炎基準に準拠しています。 防炎基準であるトレビラCSで織られています。 |
※ダニへの抗菌作用はフランスの研究機関TEC(Tests D’efficaite Insecticides)にて実証されています。
PERFORMANCE
避難搬送用具比較

| 製品 | 参考 | 介助人数 | 移動開始 までの時間 |
比較概要 | メンテナンス |
|
S-CAPEPLUS S-CAPEPLUS PREMIUM |
1人(min) 2人(max) |
最短60秒 最短90秒 |
最小1名で階段を滑り下ろして安全に降下できる。 プレミアムはガラスや瓦礫等の悪条件下でも使用可能。 頭部を固定して移動するのでより安全性が高い。 |
無し | |
|---|---|---|---|---|---|
| 介護用避難 担架シート |
2人(min) 4人(max) |
ー | 導入コストは低いが、体力的負担が高く、転倒の可能性がある。 担いで移動するため、避難に時間がかかる。 |
要 | |
| 防災用車輪付き担架 | 2人(min) 4人(max) |
ー | 担いで移動する階段移動は非常に困難。 踊り場や部屋の出口など狭い場所での旋回が不可能な場合がある。 |
要 | |
| エアバルブ付き 避難用具 |
2人(min) 4人(max) |
180秒以上※1 |
底面が固いため搬送される方にとって快適でない場合がある。 踊り場や部屋の出口など狭い場所での取り回しが難しい場合あり。 |
要 | |
| 椅子型階段 避難車 |
1人(min) 4人(max) |
300秒以上※2 | 導入コストが高く、操作トレーニングが必要だが、階段上昇もできる。 階段での下降は安全だが移動に時間がかかる。 |
年間保守料金有 要定期部品交換 要 |
※1 空気注入に3分+患者をマットに移動
※2 セッティング+患者移動
※ 当社比
HOW TO USE
エスケープシリーズの使用方法
緊急事態の備えにエスケーププラスを。
シンプルな操作性と高い効率性で
緊急避難をより安全、よりスピーディーに。
使用方法

エスケーププラスの使用方法はとても簡単。
エスケーププラスを広げて、対象者をマットの上に寝かせ、マジックテープで包み、搬送を開始します。

設置場所からエスケーププラスを取り出します。

患者様のそばにシートを広げて置きます。

患者様をマットの上に移動し、胸部をベルトで固定します。

左右のカバーを引き寄せ、右側カバーのマジックテープを左側の面に接着させます。

足元カバーと上面をマジックテープで接着させます。

足側のストラップを引いて水平移動します。

階段では、患者様の腰が1段目の階段から出たところで足元を下げます。階段に対してできるだけ直角になるよう配置し、患者様を自身に向かって水平に引いて1段ずつ降ります。 幅の広い階段では、ストラップを手放し、一気に滑り下ろすことができます。
| マットレスサイズ (含・折り畳みフラップ) |
60×210cm |
|---|---|
| 収納時サイズ① (キャリーバッグ) |
60×35×60cm |
| 収納時サイズ② (ウォールカバー) |
100×60×17cm |
| 製品重量 | 5.5kg(本体) |
| 素材 | 難燃性トレビラCS ポリエステル |
| 安全認証 | CEマーク取得 |
使用方法

エスケーププラスの使用方法はとても簡単。
エスケーププラスを広げて、対象者をマットの上に寝かせ、マジックテープで包み、搬送を開始します。

設置場所からエスケーププラスを取り出します。

患者様のそばにシートを広げて置きます。

患者様をマットの上に移動し、胸部をベルトで固定します。

左右のカバーを引き寄せ、右側カバーのマジックテープを左側の面に接着させます。

足元カバーと上面をマジックテープで接着させます。

足側のストラップを引いて水平移動します。

階段では、患者様の腰が1段目の階段から出たところで足元を下げます。階段に対してできるだけ直角になるよう配置し、患者様を自身に向かって水平に引いて1段ずつ降ります。 幅の広い階段では、ストラップを手放し、一気に滑り下ろすことができます。
| マットレスサイズ (含・折り畳みフラップ) |
60×210cm |
|---|---|
| 収納時サイズ① (キャリーバッグ) |
60×35×60cm |
| 収納時サイズ② (ウォールカバー) |
100×60×17cm |
| 製品重量 | 5.5kg(本体) |
| 素材 | 難燃性トレビラCS ポリエステル |
| 安全認証 | CEマーク取得 |
さまざまな施設に導入を推奨しています!

病院

介護老人
保健施設

工場

オフィスビル

宿泊施設

マンション
アパートメント

学校

商業施設
芸術・文化施設

スタジアム

消防・救急
厳しい環境下での災害・事故による
負傷者を安全に素早く搬送できる
タフな避難用具。
使用方法
基本的な使用方法は、「エスケープ プラス」と同じです。
エスケーププラス プレミアムには、
安全機能(ヘッドブロックとフットボード)が追加されています。
※エスケーププラスの使用方法をご覧ください。


■ヘッドブロック
着脱可能なヘッドブロックを装備。
ヘッドブロックの位置や頭を固定するベルトの位置の長さを自由に変えられるので、搬送される方の身長、頭の大きさに合わせてしっかりと頭部を固定することができます。
■フットボード
足元に当たる部分にフットボードを入れ補強効果と安定性を高めました。搬送される方がワークブーツを履いても階段下降がよりスムースに行うことができます。

底面ダイニーマ®️
防弾チョッキにも使用される高機能繊維
『ダイニーマ®️』を採用。
S-CAPUPLUS
PREMIUMの底面には高機能繊維『ダイニーマ®️』を採用しています。軽量にも関わらず鋼鉄の15倍の強さを誇り、防弾チョッキの素材として採用されている超高強力ポリエチレン繊維です。それにより、金属片、ガラス片、石片等の障害物が散乱した場面でも底面を損傷することなく、避難移動を素早く行うことが可能となりました。
車でアスファルトの路面を牽引する耐久実験においても、S-CAPEPLUS PREMIUMの底面損傷は認められませんでした。
底面ダイニーマ®️
防弾チョッキにも使用される高機能繊維
『ダイニーマ®️』を採用。
S-CAPUPLUS
PREMIUMの底面には高機能繊維『ダイニーマ®️』を採用しています。軽量にも関わらず鋼鉄の15倍の強さを誇り、防弾チョッキの素材として採用されている超高強力ポリエチレン繊維です。それにより、金属片、ガラス片、石片等の障害物が散乱した場面でも底面を損傷することなく、避難移動を素早く行うことが可能となりました。
車でアスファルトの路面を牽引する耐久実験においても、S-CAPEPLUS PREMIUMの底面損傷は認められませんでした。

工場やプラントのような、
金属や釘・ガラスの破片・鉄製の部品等が身近にあるハードな環境下でも、
負傷者を安全に素早く搬送することができます。






| マットレスサイズ | 60 × 210 × 7cm |
|---|---|
| 製品重量 | 6.5kg |
| 耐荷重 | 200kg |
| キャリーバッグ入りサイズ | 35 × 60 × 60cm |
| ウォールカバーサイズ | 60 × 100 × 17cm |
| ウォールカバー重量 | 630kg |
| 外側上部及びフラップ材質 | トレビラCSポリエステル |
| 底面材質 | ダイニーマ®️ |
| マットレス頭部材質 | ポリアラミド80% ポリエステル20% |
|---|---|
| ヘッドブロック及び 腰部固定ストラップ |
ポリアラミド80% ポリエステル20% |
| ヘッドブロック材質 |
ナイレックス100% |
| 洗濯方法 | 水温60℃まで、 ナイロン・洗剤使用不可 |
| ヘッドブロック洗濯方法 | 水温60℃まで、 ナイロン・洗剤使用不可 |
| 安全認証 | CEマーク取得 |
さまざまな施設に導入を推奨しています!

工場

オフィスビル

宿泊施設

マンション
アパートメント

学校

商業施設
芸術・文化施設

スタジアム

病院

介護老人
保健施設

消防・救急

海上自衛隊

陸上自衛隊

航空自衛隊

航空自衛隊
あらかじめマットレスの下に敷設し、
ベッドから動けない方をマットレスごと包み
安全に素早く搬送します。
使用方法

非常時にマットレスの下からフラップを引き出し
マユのように対象者を包み込みます。
エスケープポッドは最短60秒で避難移動を開始することができます。

予めベットマットレスの下にエスケープポッドを設置して置きます。

避難時、右側のカバーをマットレスの下から引き出し、患者様を覆います。

左側のカバーをマットレスの下から引き出します。

左右のカバーを引き寄せ、右側カバーのマジックテープを左側の面に接着させます。

足元のカバーをマットレスから引き出し、足元カバーと上面をマジックテープで 接着させます。

足元からストラップを取り出し、足側からゆっくり引いて患者様を床面に着地させます。

足側のストラップを引いて水平移動します。

階段では、患者様の腰が1段目の階段から出たところで足元を下げます。階段に対してできるだけ直角になるよう配置し、患者様を自信に向かって水平に引いて1段ずつ降ります。 幅の広い階段では、ストラップを手放し、一気に滑り下ろすことができます。
| 対応サイズ① (S-CAPEPOD®️) |
幅78.74cm〜96.52cm 最大長216cm |
|---|---|
| 対応サイズ② (S-CAPEPOD®️ OW) |
幅101.6cm〜124.46cm 最大長216cm |
| 耐荷重① (S-CAPEPOD®️) |
150kg |
| 耐荷重② (S-CAPEPOD®️ OW) |
300kg |
| 製品重量① (S-CAPEPOD®️) |
1.1kg |
|---|---|
| 製品重量② (S-CAPEPOD®️ OW) |
2.5kg |
| 素材 |
難燃性&抗菌防炎性 ポリエステル |
| 安全認証 | CEマーク取得 |
さまざまな施設に導入を推奨しています!

介護老人
保健施設

病院
PERFORMANCE
&
USERVOICE
導入実績・お客様の声
国内の導入事例

教育機関
小さな力で速やかな避難をサポートしてくれる避難用具
使い方もシンプルで、実際に階段階段から降ろす際に大きな力を使うことなく移動できるエスケーププラス…

教育機関
小さな力で速やかな避難をサポートしてくれる避難用具
使い方もシンプルで、実際に階段階段から降ろす際に大きな力を使うことなく移動できるエスケーププラス…

シニア事業
介護付有料老人ホーム全棟に
エスケープ製品を導入
「安心して豊かな暮らしができる高齢者住宅をつくりたい」という思いで2004年に創業、あらゆる方々の…

シニア事業
介護付有料老人ホーム全棟に
エスケープ製品を導入
「安心して豊かな暮らしができる高齢者住宅をつくりたい」という思いで2004年に創業、あらゆる方々の…
国内導入実績一覧
企業・商業施設
- 森ビル株式会社
- 六本木ヒルズ
- 虎ノ門ヒルズビジネスタワー
- 森ビル新虎通CORE
- 森美術館
- 六本木ヒルズゲートタワー
- 元麻布ヒルズフォレストタワー
- 六本木ヒルズレジデンス
- 六本木さくら坂レジデンス
- アークタワーズイーストウエスト
- フォレストテラス松濤
- 虎ノ門ヒルズレジデンスタワー
- 日本マイクロソフト株式会社
- 株式会社バンダイ・スピリッツ
- ジョーンズラング・ラ・サール株式会社
- 日鉄マイクロメタル株式会社
- 五高記念館
- シネシティザード
- シネプラザ サントムーン
- 愛宕神社
![]()
学校・教育機関
- 大阪工業大学
- 梅田キャンパス
- 大宮キャンパス
- 学内カフェテリア
- 青山学院
- 青山キャンパス
- 相模原キャンパス
- 摂南大学
- 川崎市立中央支援学校
- 武蔵野市障害者福祉課
- 渋谷区社会福祉協議会
- 総合ケアコミュニティー
病院・クリニック
- 東京済生会中央病院
- NTT東日本関東病院
- 地域医療機能推進機構 滋賀病院
- 同和会 千葉病院
- 済生会 増田病院
- 前田記念病院
- 武蔵小杉クリニック
- 新横浜クリニック
- 下北沢病院
- 内幸町診療所(帝国タワー内)
介護施設・老人ホーム・サ高住
- 株式会社アズパートナー
- アズハイム文京白山
- アズハイム光が丘
- アズハイム横浜東寺尾
- アズハイム東浦和
- 他全棟
- 若竹大寿会
- わかたけグループ内 全国10施設
- 介護付有料ホーム リエイ
- コンシェール舞浜
- コンシェール徳丸
-
介護付有料老人ホーム
ペリデ下川原 -
東京都社会福祉事業団
東村山福祉園 - 特別養護老人ホーム 和幸園
- 社会福祉法人 なごみ
- あらかわ希望の家
- 特別養護老人ホーム
ケアポート晴海 - ヘルスネットワーク 家族倶楽部
- さわやか絹の郷 信州おかや
- トラストガーデン横浜馬車道
- 島根あしたの木
有料老人ホーム花隠
海外の導入事例

病院
避難にはあえてこのマットレスを使用したいと意思表示
マキシマMC病院はオランダ エイントホーフェンの中心部2か所にある地域でトップの臨床病院です。スタ…

病院
避難にはあえてこのマットレスを使用したいと意思表示
マキシマMC病院はオランダ エイントホーフェンの中心部2か所にある地域でトップの臨床病院です。スタ…
さまざまな国で導入されています!

導入国一覧
- USA
- カナダ
- ロシア
- ドイツ
- イギリス
- スペイン
- ノルウェー
- ベルギー
- スイス
- オーストリア
- フランス
- トルコ
- ギリシャ
- サウディアラビア
- UAE
- オーストラリア
- ニュージーランド
- 日本
- 韓国
- 台湾
※2022年10月現在
導入国一覧
- USA
- カナダ
- ロシア
- ドイツ
- イギリス
- スペイン
- ノルウェー
- ベルギー
- スイス
- オーストリア
- フランス
- トルコ
- ギリシャ
- サウディアラビア
- UAE
- オーストラリア
- ニュージーランド
- 日本
- 韓国
- 台湾
※2022年10月現在
Q&A
よくある質問
- Q.階段の搬送時に対象者は背中が痛くならないの?
-
A.
エスケーププラスは厚さ7.5cmのマットが衝撃を吸収するため、階段移動時の背中への衝撃は「マッサージ機程度の感触」です。エスケープポッドは一緒に包むベッドマットの厚さによります。
- Q. アスファルトやコンクリートの地面でも使えるの?
-
A.
エスケーププラスプレミアムは使用可能です。アスファルト上を自動車で10分間引きづるテストで破損なし。ガラス、金属片などがある地面にはプレミアムがおすすめです。
- Q.エスケーププラスは階上移動に使用できますか?
-
A.
エスケープシリーズは人力と重力による移動搬送です。階段を上る時には2名以上で頭側から引き上げて移動します。
下降に比べ時間と人数を要しますが、階上移動も可能です。
- Q.耐用年数はどのくらいですか?
-
A.
避難訓練の頻度や使用又は保管の環境により異なりますが、 エスケーププラスが2015年にオランダで発売されて以来、経年劣化等の報告はされておりません。経年劣化によるヘタリを感じた場合、マットレスのみ購入することも可能です。